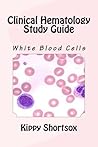
Clinical Hematology Study Guide (Clinical Hematology Study Topics Book 2)

Reader Q&A
To ask other readers questions about
Clinical Hematology Study Guide,
please sign up.
Unanswered Questions
About Goodreads Q&A
Ask and answer questions about books!
You can pose questions to the Goodreads community with Reader Q&A, or ask your favorite author a question with Ask the Author.
See Featured Authors Answering Questions
Learn more